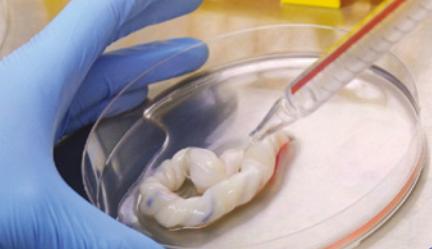

Cordlife Brands and Services
Stem Cell Banking


CORD BLOOD BANKING
Cord blood is the blood that remains in a baby’s umbilical cord and placenta. It can be collected at birth and cryopreserved so that your child has access to her own stem cells in the event of a health crisis.
CORD LINING BANKING
Cord lining contains 2 types of cells (mesenchymal stem cells and epithelial stem cells), which can provide extra protection for you and your child. Cordlife owns an exclusive licence from CellResearch Corporation to market the service.

CORD TISSUE BANKING
Cord tissue, in particular Wharton's Jelly, contains one type of stem cells. It can be collected at birth and cryogenically preserved to safeguard your baby and your family's future health.
Pregnancy & Conception


Carrier Screening
Carrier screening, usually done before or during a pregnancy. It is a genetic test used to determine if you carry a gene for certain genetic disorders.


Preimplantation Genetic Screening
A screening test performed to identify chromosomally normal embryos to help patients increase their chances of conceiving a healthy baby.


Non-Invasive Prenatal Testing (NIPT)
A screening test using whole genome sequencing to analyse cell-free foetal DNA present in maternal blood as early as 10 weeks of pregnancy to detect the risk of chromosomal abnormalities.

Newborns & Children


Baby Genetic Screening
A non-invasive screening for chromosomal abnormalities and gene variants connected to more than 200 genetic disorders in babies using cord blood.


Newborn Metabolic Screening
A screening test performed to identify more than 100 life-threatening metabolic disorders using a single urine test, without causing any harm or discomfort to your baby.


Genetic Talent Test
A non-invasive genetic test that scientifically assesses a child’s certain innate abilities and personality traits to help parents understand their child’s genetic potential.

Adults

Others

L.I.F.E Sprouts
A concept unit established to explore new ways to meet health, wellness and lifestyle needs of our existing clients and prospects, as well as to increase our customer engagement by delivering value at every milestone of their life journey.






